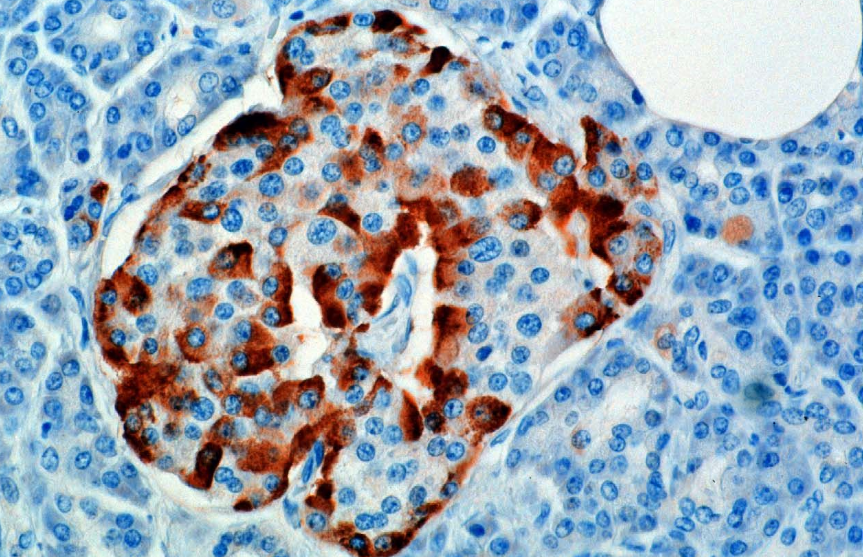

1. 이자(췌장)

당뇨를 이해하기 위해서는 췌장(이자)에 대해 알 필요가 있다. 여기서 나오는 호르몬이 당뇨에 큰 영향을 주고 있기 때문이다. 이자(胰子) 혹은 췌장(膵臟)은 소화요소를 포함한 이자액(췌액)을 샘창자로 보내고 인슐린, 글루카곤 등의 호르몬을 분비하는 배안의 뒤쪽에 가로로 길쭉하게 자리한 척추동물이 가지고 있는 기관이다.
사람 몸에 있는 췌장은 성인 기준으로 길이는 15cm 정도며, 모양은 오른쪽이 굵고 왼쪽이 가는 쐐기형이다. 그리고 사진에서 볼 수 있듯 간 아래에 있는 십이지장이 ㄷ자 모양으로 굽어진 부분 사이에 박혀있으며(췌두부쪽), 반대편 우측 끝은 복부 오른쪽 끝 비장 부근까지(췌미부쪽) 도달해 있다.
췌장 안에는 췌장에서 만들어진 이자액을 십이지장까지 운반하는 췌관이 지나고 있다. 이 췌관은 십이지장쪽에 가까워지면서 합류하다가 마지막에 주췌관과 부췌관으로 나뉘어 십이지장으로 이어진다. 주췌관은 십이지장으로 이어지기 전에 담낭에서 담즙이 흘러나오는 총담관과 합류하며, 부췌관은 십이지장의 다른 부분으로 바로 연결된다. 주췌관과 연결된 총담관은 췌장의 개구부인 십이지장유두(파터 유두(papilla of Vater))를 통해 십이지장과 연결된다. 이 십이지장 유두에는 평활근(平滑筋, smooth muscle, 근절(sarcomere)이 없는 근육)인 오디 괄약근(sphincter of Oddi)이 있어 이자액 분비를 조절한다.
1-1. 이자섬(랑게르한스 섬)

이자섬(pancreatic islets) 혹은 랑게르한스 섬(islets of Langerhans)는 췌장(이자) 내부에 섬 모양으로 산재한 내분비 세포군이다.

1869년에 독일의 병리해부학자이자 생물학자 파울 랑게르한스(Paul Langerhans, 1847~1888)이 발견했고 따라서 그의 이름을 따서 랑게르한스 섬이라 부르게 되었다.
췌장은 췌장액 아밀라아제 등 소화효소를 십이지장 안으로 분비하는 외분비선 그리고 내분비선인 이자섬(랑게르한스 섬)으로 이뤄진다. 췌장의 90% 이상은 외분비선이 차지하는데, 그 외 사이 사이에 내분비 세포 덩어리가 섬처럼 분비액에 떠서 존재하고 있다. 이렇게 10%도 안되는 곳에서 내분비 세포 덩어리가 떠있는 모습을 보고 '섬'이라고 부르게 되었다.
섬처럼 분비액 사이에 떠있는 랑게르한스 섬은 알파세포(α cell), 베타세포(β cell), 델타세포(δ cell), 엡실론세포(ε cell), PP세포(PP cell)의 5가지 세포와 랑게르한스 섬 안으로 영양소를 운반하는 혈관으로 구성된다. 여기서 알파세포는 글루카곤(glucagon)을, 베타세포는 인슐린(insulin)과 아밀린(amylin)을, 델타세포는 소마토스타틴(somatostatin)을, 엡실론 세포는 그렐린(ghrelin)을, PP세포는 췌장 폴리펩타이트(PP, pancreatic polypeptide)를 생산, 분비한다.
| 세포명 | 생산, 분비 호르몬 | 랑게르한스 섬에서의 총 비율 (인간의 랑게르한스 섬의 지름 : 100~300μm) (인간의 랑게르한스 섬의 개수 : 10~20/췌장 1mg) |
| 알파세포(α cell) | 글루카곤(glucagon) | 15~25% |
| 베타세포(β cell) | 인슐린(insulin), 아밀린(amylin) | 50~70% |
| 델타세포(δ cell) | 소마토스타틴(somatostatin, 성장 억제 호르몬) | 5~10% 미만 |
| 엡실론세포(ε cell) | 그렐린(ghrelin) | 1% 미만 |
| PP세포(PP cell) | 췌장 폴리펩타이트(PP, pancreatic polypeptide) | 2~5% 미만 |
여기서 핵심은 췌장의 내분비선 랑게르한스 섬(이자섬)에 있는 알파세포는 혈당이 감소되면 분비되는 글루카곤이라는 호르몬을, 베타세포는 혈당이 증가하면 분비되는 인슐린이라는 호르몬을 분비한다는 것이다.
2. 이자에서 나오는 호르몬 - 글루카곤과 인슐린
췌장은 내분비선과 외분비선으로 구성되며, 여기서 내분비선은 랑게르한스 섬(이자섬)이라고 부른다. 이 내분비선 이자섬에는 알파세포, 베타세포, 감마세포, 델타세포, 엡실론세포, PP세포가 있는데, 각각은 다양한 호르몬을 분비한다. 우선 각각의 호르몬이 어떤 영향을 주는지 표로 정리해봤다.
| 분비 세포 | 이름 | 영향 |
| 알파세포 | 글루카곤(glucagon) | 혈당치 높임 |
| 베타세포 | 인슐린(insulin) | 혈당치 낮춤 |
| 아밀린(amylin) | 포만감 촉진 (인슐린과 함께 분비됨) |
|
| 델타세포 | 소마토스타틴(somatostatin) (=성장호르몬 억제호르몬) |
인슐린, 글루카곤 분비 조절 성장호르몬 분비 방해 |
| 엡실론세포 | 그렐린(ghrelin) | 식욕 증가 |
| PP세포 | 췌장 폴리펩타이트(PP, pancreatic polypeptide) | 췌장 분비 활동 조절 |
2-1. 알파세포와 글루카곤
알파세포(α cell)는 혈류에서 포도당(glucose) 수치를 증가시키기 위해 혈당치를 높이는 펩타이드 호르몬인 글루카곤을 분비하는 이자의 랑게르한스 섬에서 발견되는 내분비 세포다.
앞서 말했듯 이 알파세포는 저혈당인 상황이나 혈당 수치를 높이는 아드레날린(에피네프린), 그외 아미노산이나 다양한 호르몬과 신경전달물질에 반응해 글루카곤을 생성해 혈당 수치를 높이게 자극받는다.
알파세포에서 분비되는 글루카곤은 간에 혈중 포도당 수치를 증가시키는 포도당 신생합성(GNG, gluconeogenesis)를 시작하도록 신호를 보내는 기능을 하고, 또, 인슐린 분비를 자극하는 글루카곤양펩타이드-1(GLP-1)을 생성하며 베타세포에 대한 보호와 재생 효과를 줄 수 있다. 재밌는 점은 GLP-1로 베타세포를 도울 수 있을 뿐 아니라, 베타 세포로 직접교차분화(쉽게 말해 '전환')될 수도 있다는 것이다.

그럼 이 알파세포가 분비하는 글루카곤은 어떤 호르몬일까? 어형 분석부터 해보자.
글루카곤(glucagon, GCG)은 '달콤한'이라는 뜻의 고대 그리스어 형용사 γλῠκῠ́ς[글루쿠스]와 '끌다(이끌다, 끌어오다)'라는 뜻의 고대 그리스어 동사 ᾰ̓́γω[아고]가 합친 단어로, '달콤한 것을 끌고 오는'이라는 뜻이다. 이미 어원에서 예상할 수 있다시피 이 이자(췌장)에 있는 알파세포에서 생상되는 펩타이드 호르몬인 글루카곤은 체내의 혈당 수치가 감소한 경우에 분비되어 글리코겐을 포도당으로 분해하고 혈중 포도당 수치를 증가시키는 포도당 신생합성을 촉진시켜 혈당량을 증가시키는 역할과 지방 분해를 통해 포도당 생성 속도를 조절하는 역할을 한다.
2-2. 베타세포와 인슐린

베타세포(β cell)는 인슐린과 아말린을 합성하고 분비하는 이자의 랑게르한스 섬에서 발견되는 세포다. 인간의 랑게르한스 섬에 있는 세포의 총 50~70%로 가장 많은 부분을 차지한다. 당뇨병 발병 원인을 일으키는 중요한 세포로, 이 세포의 수와 세포의 기능에 따라서 제1형 당뇨병, 제2형 당뇨병 등으로 병의 정도가 달라진다.
이 베타세포의 주요 기능은 정의에서도 말했듯 인슐린과 아말린을 생성하고 방출하는 것이다. 이렇게 생성방출된 인슐린과 아말린은 각각 다른 방법으로 혈당수치를 감소시킨다. 이 베타세포가 파괴되며 몸에서 인슐린을 거의 분비하지 못하게 되어 고혈당이 된다면 제1형 당뇨병이 되고, 베타세포가 여전히 인슐린을 분비할 수 있지만 그래도 인슐린이 상대적으로 부족하고, 많이 분비하더라도 그 인슐린이 효과적으로 능력을 발휘하지 못해 고혈당이 된다면 제2형 당뇨병이 된다.

그럼 이 베타세포가 분비하는 인슐린은 어떤 호르몬일까? 어형 분석부터 해보자.
인슐린(Insulin)은 '섬'을 뜻하는 라틴어 여성 명사 īnsula[인슐라]에서 유래했다. 여기서 섬은 예상했겠지만 이 물질이 만들어지는 이자섬(랑게르한스 섬)을 말한다.
이자섬의 베타세포에서 분비되는 펩타이드 호르몬인 인슐린은 혈중을 흐르는 포도당이 간, 지방 세포, 골격근 세포 등에 흡수되도록 촉진해 혈당 수치를 낮추고 탄수화물과 지방, 단백질의 대사를 조절하는 역할을 한다. 이 인슐린 포도당이 세포 속으로 들어가 에너지 원이 될 수 있도록 문을 여는 열쇠 역할을 한다고 보면 된다.

인슐린이 혈액 속의 포도당을 세포 안으로 나르는 전달자 중 하나인 GLUT4(GLUcose Transporter type 4, 포도당 수송기 4)를 활성화 시켜 그 문이 열리면 그 세포 안으로 포도당이 들어가는 식이다.
3. 혈당이 조절되는 원리 : 인슐린-글루카곤 길항작용

신체는 세포 호흡을 통해 영양소를 ATP로 전환한다. 이 때 영양소를 ATP로 바꾸는 과정에서 포도당이 필요한데, 이 포도당은 우리 몸에 적절한 수준으로 존재해야 한다. 만일 혈중 포도당 수치가 높으면 고혈압처럼 세포에 손상을 줄 수 있어서 포도당 수치를 줄여야 하며, 혈중 포도당 수치가 낮으면 세포가 세포 호흡을 할 에너지가 부족해 힘을 잃어 가기에 포도당 수치를 늘려야 한다. 여기서 이자 내 랑게르한스 섬의 베타세포에서 분비되는 인슐린과 알파세포에서 분비되는 글루카곤의 길항작용(antagonism)으로 체내 혈당 농도가 조절되는 것이다.
식사 직후와 같이 혈당 수치가 높을 때, 인슐린이 이자의 베타세포에서 방출되어 혈당 농도를 감소시킨다. 간에서 글리코겐 합성을 자극한다던지, 간과 지방 조직에 의한 포도당 흡수를 촉진시킨다던지, 또 포도당 분해 속도를 증가시키는 활동을 통해 우리 몸의 높아진 혈당 수치를 감소시킨다.
반대로 운동 직후와 같이 혈당 수치가 낮을 때, 글루카곤이 이자의 알파세포에서 방출되어 혈당 농도를 증가시킨다. 간에서 글리코겐 분해를 자극하거나, 간과 지방 조직에 의한 포도당 방출을 촉진시키고, 또 포도당 분해 속도를 감소시키는 활동을 통해 우리 몸의 낮아진 혈당 수치를 증가시킨다.
| 혈당 수치가 높을 때(식사 직후 등) | 혈당 수치가 낮을 때(운동 직후 등) |
| 베타세포에서의 인슐린 분비 | 알파세포에서의 글루카곤 분비 |
| 간에서의 글리코겐 합성 자극 간과 지방 조직에 의한 포도당 흡수를 촉진 포도당 분해 속도 증가 촉진 |
간에서의 글리코겐 분해 자극 간과 지방 조직에 의한 포도당 방출 촉진 포도당 분해 속도 감소화 |
당뇨와 운동이 어떤 연관이 있는지 알아보기 전에 우리 몸에서 그 당뇨의 원인이 되는 혈당을 조절하는 호르몬 2가지와 그 호르몬이 나오는 이자의 특징과 구조를 간단하게 정리해봤다. 다음엔 당뇨병이 어떤 병인지, 또 운동과 당뇨가 어떻게 연관되어 있는지를 적으며 이 시리즈를 정리하도록 하겠다.
'과학&기술 > 생물학, 의학' 카테고리의 다른 글
| 체력관리 정리 - 고혈압과 운동 (0) | 2022.11.21 |
|---|---|
| 체력관리 정리 - 당뇨와 운동(2) 당뇨병과 당뇨병에 대한 운동 효과 (0) | 2022.10.31 |
| 체력관리 정리 - 신체활동의 이점과 위험요인 (0) | 2022.10.17 |
| 신체활동의 범위와 운동 목표를 정하는 공식 (0) | 2022.09.08 |
| 서울에 러브버그가 나타났다고?!?! (0) | 2022.07.03 |



